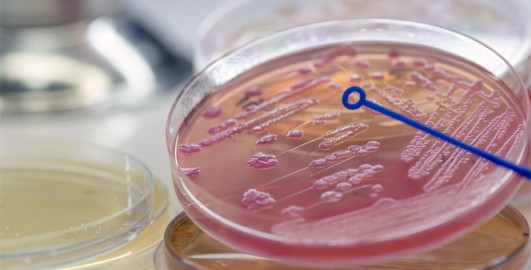
Laboratory Skills for Biology and Health

school providing you with 18 hours of ‘hands on’ experience with several widely used
molecular and microbiological techniques to investigate bacterial antibiotic
resistance. Techniques will include PCR, qPCR, agarose gel
electrophoresis, bacterial plasmid transformation, micro-pipette handling,
sterile working, serial dilution for bacterial enumeration and analysis of GFP
expression. The laboratory protocols are designed to develop both good
laboratory practice (GLP) and good microbiological practice (GMP).